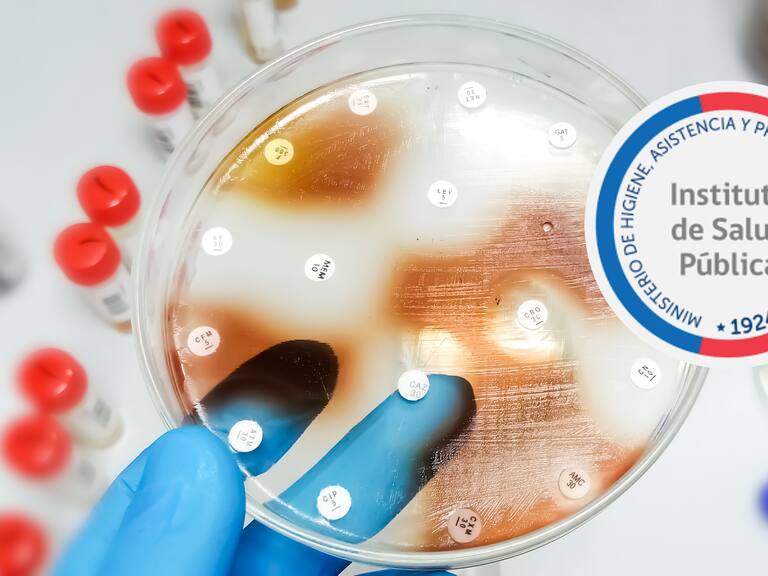
hdr

FOTO. ISP ordena retiro de jabón líquido farmacéutico tras detectar peligrosa bacteria en dos pacientes
El retiro del lote 1080186240 fue dispuesto tras la identificación de Burkholderia, lo que pone en alerta sobre un posible brote recurrente ya que en 2022 ocurrió lo mismo.
hdr
Santiago de Chile
El Instituto de Salud Pública (ISP) ha ordenado el retiro preventivo de un lote del jabón líquido farmacéutico Dichlorexan Jabón Líquido 2% de Difem Laboratorios, tras detectar bacterias en dos pacientes.
El lote afectado, con número 1080186240, se comercializa en envases de un litro. El ISP señaló que los usuarios pueden identificar el lote por su número de serie inscrito en el frasco.
La decisión se tomó debido a la vinculación del producto con un brote de infecciones por Burkholderia cepacia (CBC), una bacteria que puede causar infecciones crónicas en personas con fibrosis quística o sistemas inmunitarios comprometidos.

Foto www.dipromed.cl
A través de su sitio web, el ISP indicó que “el agente Burkholderia lata clon 8, idéntico al encontrado previamente en otro lote del mismo producto de Difem Laboratorios S.A., durante 2022″, fue detectado en los pacientes.
Instan a revisar número de lotes
Este brote recuerda el episodio de 2022, cuando el Ministerio de Salud emitió una circular alertando sobre la posible contaminación del producto, señalando que “la aparición de casos de infecciones por el mismo agente en distintos establecimientos" sugería un brote multicéntrico de origen común.
El ISP recomendó a los usuarios dejar de utilizar el producto si poseen el lote afectado y reemplazarlo por otro con un número de serie diferente.
Asimismo, instó a los establecimientos de salud, farmacias y distribuidores a “revisar si disponen de existencias del lote afectado y, en caso afirmativo, segregarlos para retirarlos y devolverlos al laboratorio por los canales habituales".
Sigue a ADN.cl en Google Discover
Recibe nuestros contenidos directamente en tu feed.























